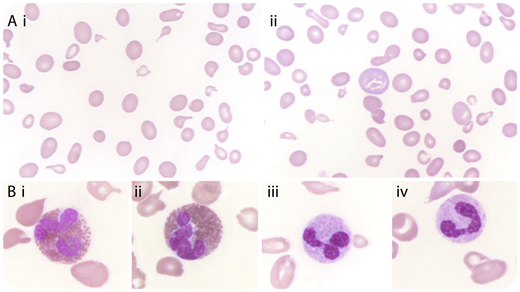
A 51-year-old Malian man with no remarkable medical history presenting with pancytopenia was referred to our department as a suspected case of acute leukemia. His leukocyte count was 2.8 × 109/L with 0.4 × 109/L neutrophils; platelets were 41 × 109/L. His hemoglobin level was 4.8 g/dL with low reticulocyte count. The diagnosis of vitamin deficiency was not the foremost hypothesis because a very mild macrocytosis (101 fL) was measured, yet with a high anisocytosis (red cell distribution width at 41%; normal value, <15%). The examination of the peripheral blood smear confirmed the heterogeneity of the red cell size, with macrocytes, macroovalocytes, and numerous schistocytes (panels Ai-ii; original magnification ×630, May-Grünwald Giemsa stain). Interestingly, neutrophil nuclei were normal, whereas the rare eosinophils observed displayed 3 to 4 lobes (panels Bi-iv; original magnification ×1000, May-Grünwald Giemsa stain), strongly suggesting the diagnosis of vitamin deficiency. This latter was confirmed by a low vitamin B12 level of 56 ng/L (normal values, 250-550 ng/L), which turned out to be related to a pernicious anemia. / Most hematologists are aware of the relevance of hypersegmented neutrophil nuclei for vitamin deficiency diagnosis. However, the level of hypersegmentation is not related to the depth of the deficiency, as illustrated here. This case highlights the relevance of careful blood smear examination, looking for hypersegmentation even in eosinophils, which can avoid costly investigation for exploration of unexplained hemolytic anemia.

A 51-year-old Malian man with no remarkable medical history presenting with pancytopenia was referred to our department as a suspected case of acute leukemia. His leukocyte count was 2.8 × 109/L with 0.4 × 109/L neutrophils; platelets were 41 × 109/L. His hemoglobin level was 4.8 g/dL with low reticulocyte count. The diagnosis of vitamin deficiency was not the foremost hypothesis because a very mild macrocytosis (101 fL) was measured, yet with a high anisocytosis (red cell distribution width at 41%; normal value, <15%). The examination of the peripheral blood smear confirmed the heterogeneity of the red cell size, with macrocytes, macroovalocytes, and numerous schistocytes (panels Ai-ii; original magnification ×630, May-Grünwald Giemsa stain). Interestingly, neutrophil nuclei were normal, whereas the rare eosinophils observed displayed 3 to 4 lobes (panels Bi-iv; original magnification ×1000, May-Grünwald Giemsa stain), strongly suggesting the diagnosis of vitamin deficiency. This latter was confirmed by a low vitamin B12 level of 56 ng/L (normal values, 250-550 ng/L), which turned out to be related to a pernicious anemia.
Most hematologists are aware of the relevance of hypersegmented neutrophil nuclei for vitamin deficiency diagnosis. However, the level of hypersegmentation is not related to the depth of the deficiency, as illustrated here. This case highlights the relevance of careful blood smear examination, looking for hypersegmentation even in eosinophils, which can avoid costly investigation for exploration of unexplained hemolytic anemia.
A 51-year-old Malian man with no remarkable medical history presenting with pancytopenia was referred to our department as a suspected case of acute leukemia. His leukocyte count was 2.8 × 109/L with 0.4 × 109/L neutrophils; platelets were 41 × 109/L. His hemoglobin level was 4.8 g/dL with low reticulocyte count. The diagnosis of vitamin deficiency was not the foremost hypothesis because a very mild macrocytosis (101 fL) was measured, yet with a high anisocytosis (red cell distribution width at 41%; normal value, <15%). The examination of the peripheral blood smear confirmed the heterogeneity of the red cell size, with macrocytes, macroovalocytes, and numerous schistocytes (panels Ai-ii; original magnification ×630, May-Grünwald Giemsa stain). Interestingly, neutrophil nuclei were normal, whereas the rare eosinophils observed displayed 3 to 4 lobes (panels Bi-iv; original magnification ×1000, May-Grünwald Giemsa stain), strongly suggesting the diagnosis of vitamin deficiency. This latter was confirmed by a low vitamin B12 level of 56 ng/L (normal values, 250-550 ng/L), which turned out to be related to a pernicious anemia.
Most hematologists are aware of the relevance of hypersegmented neutrophil nuclei for vitamin deficiency diagnosis. However, the level of hypersegmentation is not related to the depth of the deficiency, as illustrated here. This case highlights the relevance of careful blood smear examination, looking for hypersegmentation even in eosinophils, which can avoid costly investigation for exploration of unexplained hemolytic anemia.
For additional images, visit the ASH Image Bank, a reference and teaching tool that is continually updated with new atlas and case study images. For more information, visit http://imagebank.hematology.org.